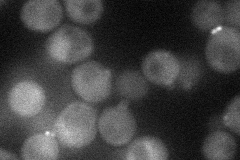
YPL242C
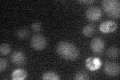
YPL242C

View description
Essential protein required for determination of budding pattern, promotes localization of axial markers Bud4p and Cdc12p and functionally interacts with Sec3p, localizes to the contractile ring during anaphase, member of the IQGAP family
Localization:
Intensity:
Fold change:
Significance:
-
C’ GFP library in SD

bud neckN/A -
N' NOP1pr-GFP in SD
bud neck32.9444 -
N' TEF2pr-mCherry in SD

bud neck8.69777 -
N' NATIVEpr-GFP in SD

bud neck19.0992 -
N' TEF2pr-VC and Cyto-VN in SD

below threshold24.5568 -
C’ GFP library in SD+DTT

bud neck15.580.96No -
C’ GFP library in SD+H2O2

bud neck21.191.3No -
C’ GFP library in Starvation Media
bud neck18.281.12No -
C’ GFP library on the background of Pup2-DaMP

bud neck -
C’ GFP library on the background of CCT mutant

bud neck17.02721.05208No
